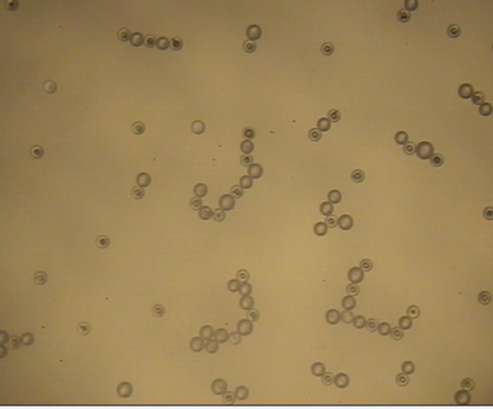
Molecular-like hierarchical self-assembly of particle mixture

Figure 1. Glass particle assembly at an air-oil interface. The mean radius of the particles is 63 µm. (i) Particles self-assembled under the action of lateral capillary forces alone. The lattice lacks long-range order and contains many defects.
(Collaborative project with Dr. Nadine Aubry)
The goal of this project is to assemble monolayers with defect-free ordering and variable lattice spacing, and then transferring them to a solid substrate (see the figures below). We are using direct numerical simulations (DNS) and experiments to model the electric forces that act on particles trapped in fluid-liquid interfaces when an electric field is applied normal to the interface. The aim is to determine the dependence of the vertical electric forces on spherical and prismatic particles for a broad range of parameters (for various fluid and particles and electric field intensities). We are also developing models for the capillary and lateral electric forces and the lattice gap. Another aim is to determine conditions under which the vertical electrostatic force pushes particles away from the interface. This is a phenomenon which has to be prevented for the purpose of self-assembly, but may be desired if one seeks to clean interfaces of trapped particles.
We have recently developed a novel technique for coating the surface of a material with a monolayer (single layer) of particles to optimize its mechanical, thermal, electrical, and optical properties. The technique involves the self-assembly of a particle monolayer on a fluid-liquid interface to obtain a defect-free lattice structure with desired lattice spacing, and then transferring the monolayer to a solid substrate.

|

|
Figure 2. (ii) When a voltage of 2000 V is applied, particles move away from each other and form a triangular lattice in which the distance between the particles is approximately 1.6 times the particle radius. (iii) The applied voltage is increased to 5000 V. The distance between particles increases to 6.2 times the particle radius.

|

|
Figure 3. Formation of flexible resin films with particle monolayers embedded on their surfaces. The monolayers were self-assembled on the surface of a UV curable resin by applying an electric field in the direction normal to the interface. (Left) A solidified resin film with an embedded monolayer of 63 µm particles. The film thickness is about 1 mm. (Right) A magnified view of the film. The lattice spacing of the monolayer is around 4R (R being the radius of the particles).

|

|
|
Figure 4. Molecular-like hierarchical self-assembly of particle mixture—self-assembled arrangements depend on particles sizes and their properties (i) 71 µm plastic and 150 µm glass particles on corn oil and the larger particles are more intensely polarized (ii) 20 µm glass and 71 µm plastic particles on corn oil and the smaller particles are more intensely polarized (iii) 63 µm glass and 71 µm plastic particles on corn oil and the particles self-assembled to form chain like structures in which the positively and negatively polarized particles are arranged alternately.